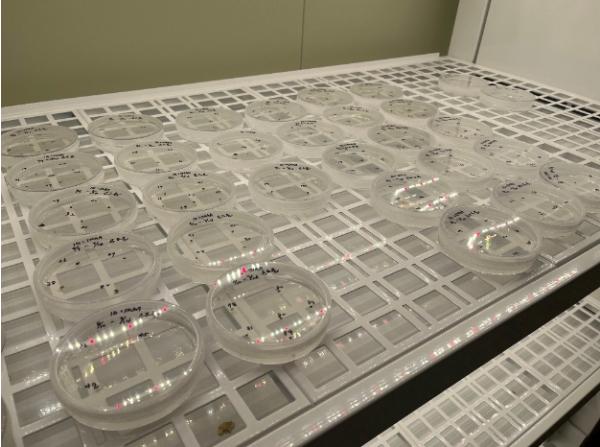

- 관련법
- 저작권등록
- 음반발매
- 행사안내
- 이건안돼
- 이건필수
- 씽어즈뉴스
- 환경
- 종합
Copyrights ⓒ singers news 씽어즈뉴스 & www.mte.kr, 무단 전재 및 재배포 금지

| Singers News | 제1사업자등록번호: 264-17-02556 |서울특별시 양천구 남부순환로 70길 12-8 금호B 102호 | |제2사업자등록번호: 378-43-00837 | 서울특별시 금천구 가산동345-33 에이스하이엔드타워7차 1003호 | 신문등록번호: 서울, 아54804 |신문등록일: 2023.4.18 | 통신판매신고: 제2023-서울양천-0262호 | 발행인: 홍석빈 | 편집인: 홍석빈 | 청소년보호책임자: 홍석빈 | 대표전화 02-2602-2814 | 대표폰 010 -3535 -2814 | 제보폰 010 -6565 -2814 | 전화노래방 010-8698 -2814 |이메일 embctourtv@gmail.com | 이메일 무단수집거부 | 불편신고 | 광고문의
![]() | |